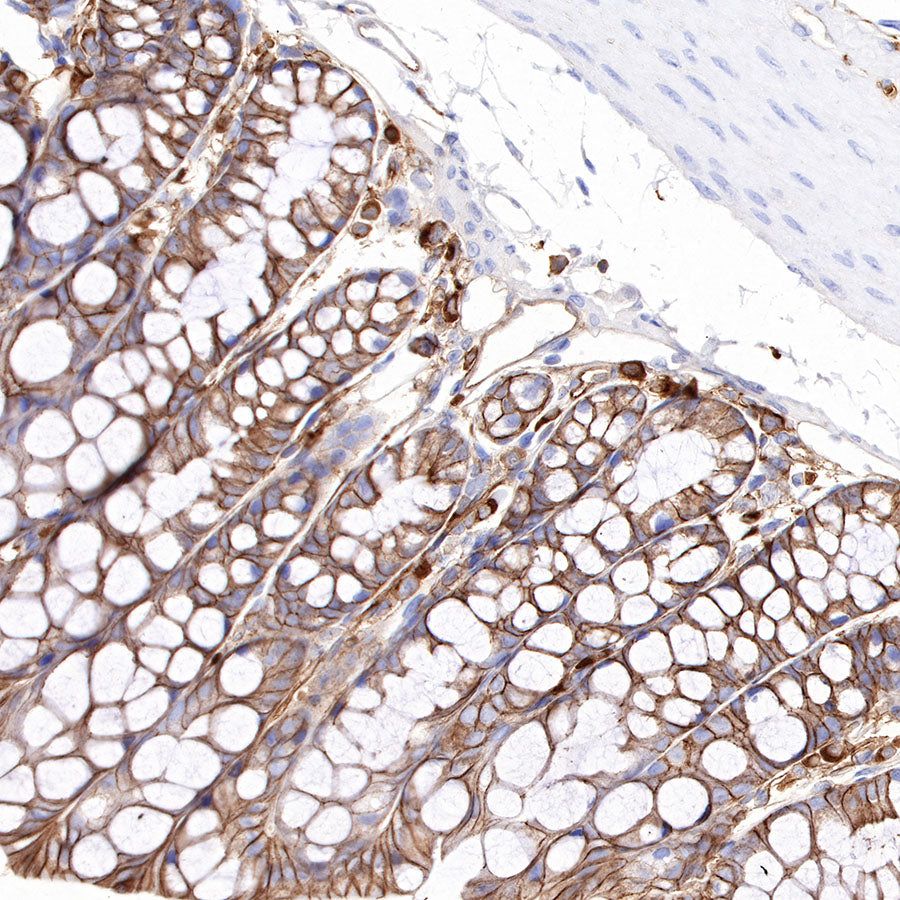

CD38 Rabbit mAb at 1/25 dilution (0.2 µg) immunoprecipitating CD38 in 0.4 mg mouse spleen lysate.
Western blot was performed on the immunoprecipitate using CD38 Rabbit mAb at 1/1000 dilution.
Secondary antibody (HRP) for IP was used at 1/1000 dilution.
Lane 1: mouse spleen lysate 10 µg (Input)
Lane 2: CD38 Rabbit mAb IP in mouse spleen lysate
Lane 3: Rabbit monoclonal IgG IP in mouse spleen lysate
Predicted MW: 34 kDa
Observed MW: 39 kDa
Product Details
Product Details
Product Specification
| Host | Rabbit |
| Antigen | CD38 |
| Synonyms | 2'-phospho-ADP-ribosyl cyclase, 2'-phospho-cyclic-ADP-ribose transferase, ADPRC 1, cADPR hydrolase 1, I-19, NIM-R5 antigen |
| Immunogen | Synthetic Peptide |
| Location | Membrane |
| Accession | P56528 |
| Clone Number | SDT-290-45 |
| Antibody Type | Rabbit mAb |
| Application | WB, IHC-P, IP, IF |
| Reactivity | Ms |
| Purification | Protein A |
| Concentration | 0.05mg/ml |
| Physical Appearance | Liquid |
| Storage Buffer | PBS, 40% Glycerol, 0.05% BSA, 0.03% Proclin 300 |
| Stability & Storage | 12 months from date of receipt / reconstitution, -20 °C as supplied |
Dilution
| application | dilution | species |
| IHC-P | 1:1600 | |
| WB | 1:1000 | |
| IF | 1:2000 | |
| IP | 1:25 |
Background
CD38 (cluster of differentiation 38), also known as cyclic ADP ribose hydrolase is a glycoprotein found on the surface of many immune cells (white blood cells), including CD4+, CD8+, B lymphocytes and natural killer cells. CD38 functions in cell adhesion, signal transduction and calcium signaling. The loss of CD38 function is associated with impaired immune responses, metabolic disturbances, and behavioral modifications including social amnesia possibly related to autism. The CD38 protein is a marker of cell activation. It has been connected to HIV infection, leukemias, myelomas, solid tumors, type II diabetes mellitus and bone metabolism, as well as some genetically determined conditions.
Picture
Picture
IP

Immunofluorescence

IF shows positive staining in paraffin-embedded mouse spleen. Anti-CD38 antibody was used at 1/2000 dilution (Green) and incubated overnight at 4°C. Goat polyclonal Antibody to Rabbit IgG - H&L (Alexa Fluor® 488) was used as secondary antibody at 1/1000 dilution. Counterstained with DAPI (Blue). Heat mediated antigen retrieval with EDTA buffer pH9.0 was performed before commencing with IF staining protocol.